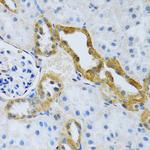
SLC4A5 Antibody in Immunohistochemistry (Paraffin) (IHC (P))

Search
Invitrogen
SLC4A5 Polyclonal Antibody
{{$productOrderCtrl.translations['antibody.pdp.commerceCard.promotion.promotions']}}
{{$productOrderCtrl.translations['antibody.pdp.commerceCard.promotion.viewpromo']}}
{{$productOrderCtrl.translations['antibody.pdp.commerceCard.promotion.promocode']}}: {{promo.promoCode}} {{promo.promoTitle}} {{promo.promoDescription}}. {{$productOrderCtrl.translations['antibody.pdp.commerceCard.promotion.learnmore']}}
图: 1 / 4
SLC4A5 Antibody (PA5-87897) in IHC (P)

Please note: We are reviewing Western blot images included in the antibody testing data in our catalog, including those provided by third parties. Unless expressly labeled or annotated as “raw-unedited”, Western blot images included in the antibody testing data in our catalog may have been edited, optimized or otherwise adjusted for presentation.
产品信息
PA5-87897
种属反应
宿主/亚型
分类
类型
抗原
偶联物
形式
浓度
规格
纯化类型
保存液
内含物
保存条件
运输条件
RRID
产品详细信息
Immunogen sequence: DFIFSQHDLA WIDNILPEKE KKETDKKRKR KKGAHEDCDE EPQFPPPSVI KIPMESVQSD PQNGIHCIAR KRSSSWSYSL; Positive Samples: LO2, U-87MG, SW480, SGC-7901, Mouse kidney; Cellular Location: Apical cell membrane, Multi-pass membrane protein
靶标信息
This gene encodes a member of the sodium bicarbonate cotransporter (NBC) family, part of the bicarbonate transporter superfamily. Sodium bicarbonate cotransporters are involved in intracellular pH regulation and electroneural or electrogenic sodium bicarbonate transport. This protein is thought to be an integral membrane protein. Multiple transcript variants encoding different isoforms have been found for this gene, but the biological validity of some variants has not been determined.
仅用于科研。不用于诊断过程。未经明确授权不得转售。
篇参考文献 (0)
生物信息学
蛋白别名: Electrogenic sodium bicarbonate cotransporter 4; electrogenic sodium bicarbonate cotransporter NBC4c; slc4a5 {ECO:0000312|RGD:1303009}; sodium bicarbonate transporter 4; Solute carrier family 4 member 5
基因别名: C330006M16; C330016K18Rik; NBC4; Slc4a5
UniProt ID: (Rat) Q6RI88
Entrez Gene ID: (Rat) 297386, (Mouse) 232156




